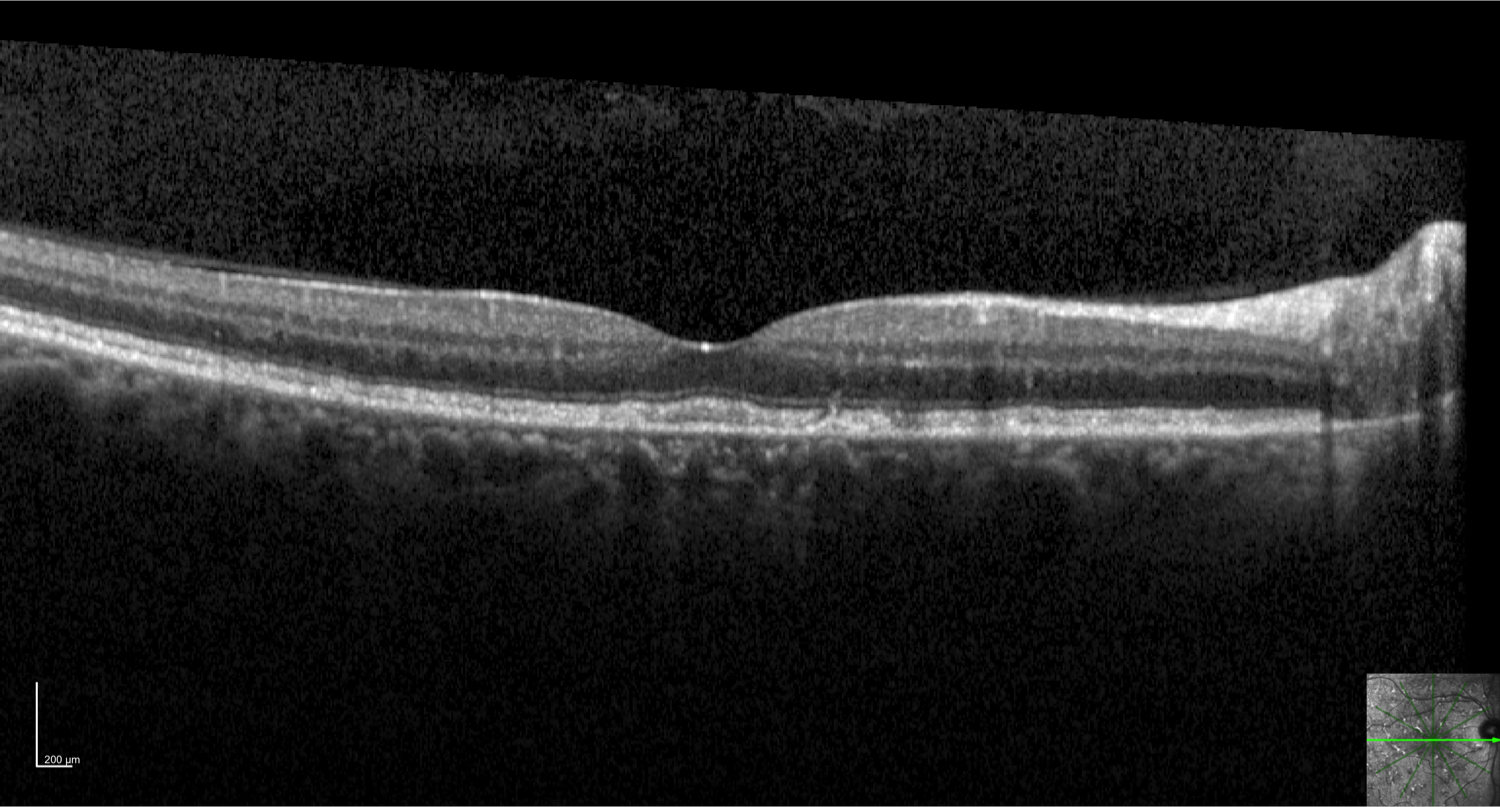

Big 14 Self-Assessment
Case 7
Case 7 is a 63 year old woman with 20/25 vision. She has many similarly affected relatives including one of her parents. Some yellow flecks were first observed in her retinas in her 20’s and there is now an extensive network of reticular yellow deposits throughout the posterior pole.